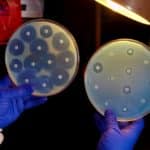

Home Search
clinical research - search results
If you're not happy with the results, please do another search
GSK Hiring M.Sc. / Ph.D Biostatistics Candidates | Apply Online
GSK Hiring M.Sc. / Ph.D Biostatistics Candidates | Apply Online
GSK is a science-led global healthcare company with a mission to help people do more,...
Zika Diaries: Compounds that inhibit Zika virus replication identified by NCAT, a part of...
Zika Diaries: Compounds that inhibit Zika virus replication identified by NCAT, a part of NIH
Researchers at the National Center for Advancing Translational Sciences (NCATS)...
Plant Biotechnologist Required @ HiMedia Laboratories Pvt. Ltd.
Plant Biotechnologist Required @ HiMedia Laboratories Pvt. Ltd.
HIMEDIA LABORATORIES is a leading manufacturer of products for microbiology, parasitology, immunology, serology, molecular biology, virology and...
No More Pain – Insulin Pill Could Make Diabetes Treatment ‘Ouchless’
No More Pain - Insulin Pill Could Make Diabetes Treatment 'Ouchless'
Every day, millions of Americans with diabetes have to inject themselves with insulin to...
Admissions Open For Ph.D. Programme 2016-2017 @ Sanjay Gandhi Postgraduate Institute of Medical Sciences...
Admission to Ph.D. Programme 2016-2017 @ Sanjay Gandhi Postgraduate Institute of Medical Sciences (SGPGI)
Sanjay Gandhi Postgraduate Institute of Medical Sciences (SGPGI), Lucknow is a tertiary-care, superspecialty...
Scientists Identify New, Sometimes Lethal, Inflammatory Disease
Scientists at the NIH report the discovery of a rare and sometimes lethal inflammatory disease that primarily affects young children. They have also identified...
Brain Damage Through Zika Virus’ Congenital Infection Goes Beyond Microcephaly
A recent study published by Brazilian researchers from the D'Or Institute for Research and Education (IDOR), Federal University of Rio de Janeiro (UFRJ), Institute...
Register for the Hands on Confocal Microscopy Imaging Basic Course- 2016
Register for the Hands on Confocal Microscopy Imaging Basic Course- 2016
TRPVB is an unique partnership programme between Department of Biotechnology (DBT) and Tamil nadu...
Study Sounds Alarm on Representation of Minorities in Genome Databases
Study Sounds Alarm on Representation of Minorities in Genome Databases
The racial distribution of research subjects is a long-standing, well-discussed problem, notably in the clinical...
Can Eye Colour Really Determine Your Risk for Cancer?
Can Eye Colour Really Determine Your Risk for Cancer?
Clinical and epidemiological data have always pointed to eye cancer being more common among those individuals...
Injectable Gels Could Prevent Repetitive Heart Failures
Injectable Gels Could Prevent Repetitive Heart Failures
During a heart attack, clots or narrowed arteries block blood flow, harming or killing cells within the tissue....
Monkeys Now Protected Against Lethal Ebola Sudan Infection
Monkeys Now Protected Against Lethal Ebola Sudan Infection
Researchers at The University of Texas Medical Branch at Galveston, in collaboration with Arbutus Biopharma Corporation, have...
A Lens Device To Test The Suitability Of Lens Implants
A Lens Device To Test The Suitability Of Lens Implants
Researchers in Spain have developed a hand-held device to help patients with cataracts visualize how...
Scientists Identify Genes Responsible For Cardiometabolic Disease
Scientists Identify Genes Responsible For Cardiometabolic Disease
In a study being published in the August 19 issue ofScience, researchers from the Icahn School of Medicine...
More Scientific Evidence That ‘Healthy Obesity’ May Be A Myth
More Scientific Evidence That 'Healthy Obesity' May Be A Myth
The term "healthy obesity" has gained traction over the past 15 years, but scientists have...